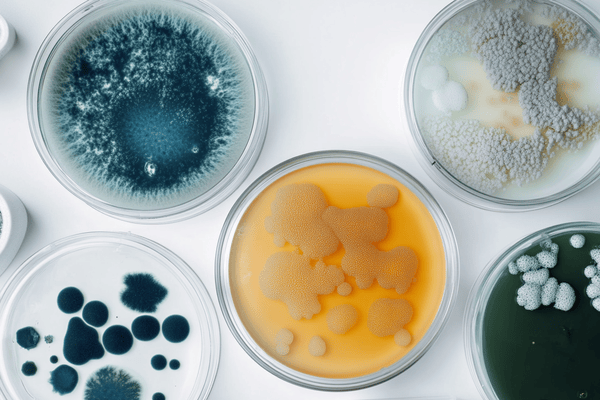

Energy Industry Articles
Latest Articles
Claims Management
The Future of Workers Compensation Claim Systems
2019-09-27 | Christopher E Mandel
The Future of WC Claim Systems—Chris Mandel reviews Scenarios for the 2030s: Threats and Opportunities for Workers' Compensation Systems.
Environmental
In Search of Sasquatch and Construction Defect Insurance
2019-09-27 | David Dybdahl
Both are more than elusive, they are nonexistent, per David Dybdahl.
Claims Management
Federal Terrorism Reinsurance Claim Recovery
2019-06-28 | Christopher E Mandel
Christopher Mandel reviews the history and the Federal Terrorism Reinsurance claims process.
Regulation and Compliance
Warren Buffett Likes Insurance Companies
2019-06-28 | Aaron E Lunt
Warren Buffett Likes Insurance Companies—Aaron Lunt looks at the attraction to and how insurers make money.
Regulation and Compliance
What Is an Insurance Model Law?
2019-05-17 | Aaron E Lunt
What Is an Insurance Model Law?—Do you know how insurance laws develop? Aaron Lunt explains the process.
Catastrophe Risk Management
Natural Catastrophe Management
2019-05-03 | Joe DiRubbo
The risk of a natural catastrophe and secondary perils is a big one. Joe DiRubbo examines the issues.
Claims Management
Examining WC Waivers of Subrogation
2019-04-12
While often required by contract, waivers pose significant risk to subcontractors' loss experience. Glenn Brown explains.
Environmental
Avoid Common Errors with Environmental Risks and Insurance
2019-04-12 | David Dybdahl
David Dybdhal shows why insurance buyers are often inadequately insured for contamination risks.
Claims Management
WC Court Rulings, Legislation, and Advocacy-Driven Claim Outcomes
2019-03-29 | Christopher E Mandel
WC Court Rulings, Legislation, and Advocacy-Driven Claim Outcomes—Worker advocacy is worth the investment and does have an impact, per Chris Mandel.
Environmental
Mold Damage from Allegedly Defective Work Excluded from CGL Coverage
2019-03-08 | Kent Holland
The homeowners pollution and mold exclusions also applied. Kent Holland explains.
Claims Management
The Future of Workers Compensation Claim Systems
2019-09-27 | Christopher E Mandel
Claims Management
WC Court Rulings, Legislation, and Advocacy-Driven Claim Outcomes
2019-03-29 | Christopher E Mandel
Environmental
Mold Damage from Allegedly Defective Work Excluded from CGL Coverage
2019-03-08 | Kent Holland